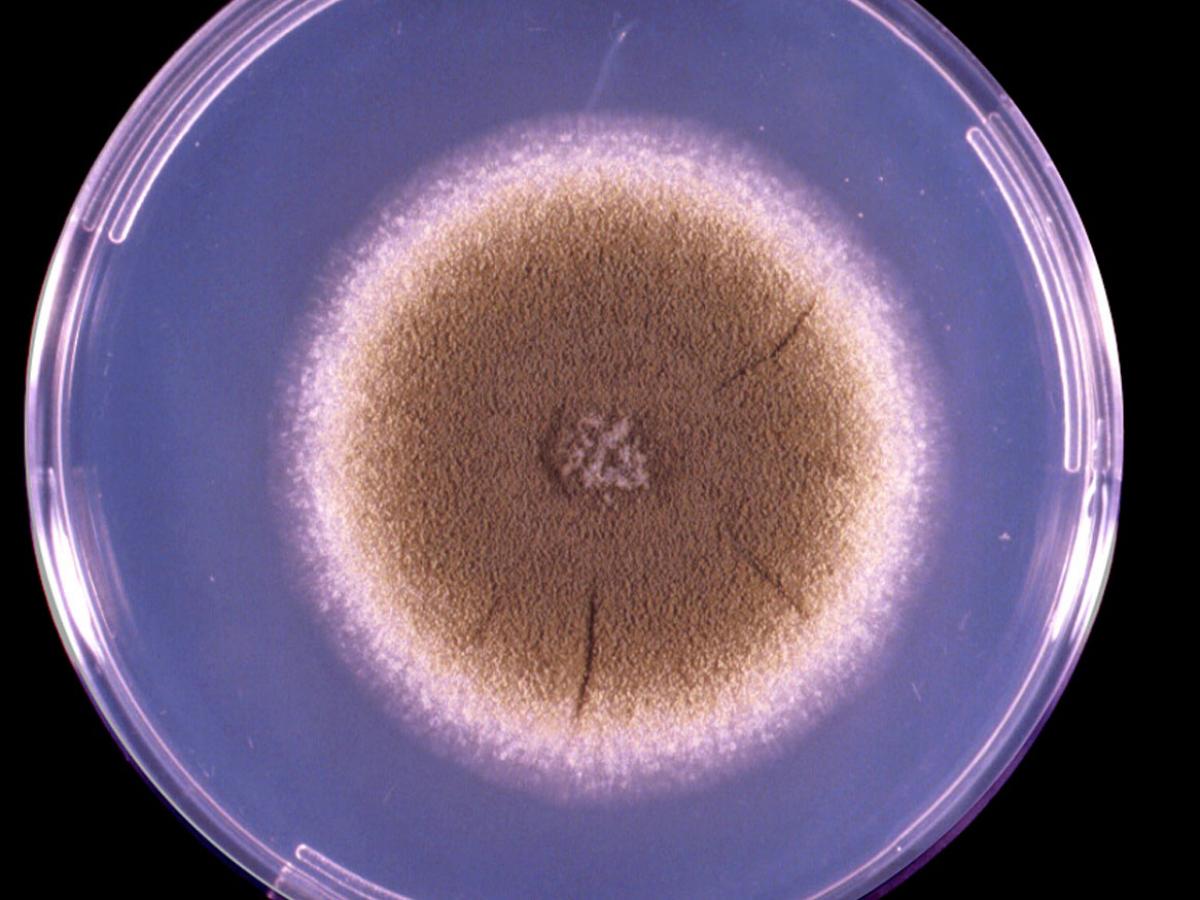
Culture

Unknown 7
Mould identification: a virtual self assessment
Case history
A 61-year-old man with acute myeloid leukaemia presented with chest pain and dyspnoea. Computed tomography revealed diffuse bilateral infiltrates which were considered to be suspicious for an invasive pulmonary aspergillosis of the left upper lobe. A biopsy was taken which showed the presence of fungal elements and the culture shown below was isolated.

Direct microscopy (methenamine silver stain)
Culture

Microscopy